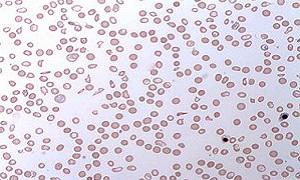

Press release
Paroxysmal Nocturnal Hemoglobinuria (PNH) Treatment Market offers huge growth opportunities for the future | Akari Therapeutics, Ra Pharmaceuticals, Alexion Pharmaceuticals, Apellis Pharmaceuticals, Ra Pharmaceuticals
This study provides insights about the Paroxysmal Nocturnal Hemoglobinuria (PNH) Treatment Market in regards to its uses and benefits. We at Crystal Market Research (CMR) provide updated information that is beneficial in decision making regarding business investments.Competitive Analysis:
The leading players in the market are Akari Therapeutics, Ra Pharmaceuticals, Alexion Pharmaceuticals, Apellis Pharmaceuticals, Ra Pharmaceuticals
Request Exclusive Sample Copy of Report at @ https://www.crystalmarketresearch.com/report-sample/HC111922
Market Segmentation:
Based on treatment, allogeneic stem cell transplantation is the known to be the only effective treatment for PNH patients. Clinical results from different SCT programs reflect that this technique is constrained to a limited number of patients who are suffering from comparative rare issues.
Regional Insights:
North America(U.S., Canada, Mexico)
Europe(German, UK, France, Russia, Italy, Rest of Europe)
Asia-Pacific(China, Japan, South Korea, India, Southeast Asia, Rest of Asia-Pacific)
South America(Brazil, Argentina, Columbia, South Africa, Rest of South America)
Middle East and Africa(Saudi Arabia, UAE, Egypt, Nigeria, South Africa, Rest of MEA)
Industry Outlook:
The Paroxysmal Nocturnal Hemoglobinuria (PNH) Treatment Market has encountered significant development over the recent years and is anticipated to grow tremendously over the forecast period. Paroxysmal nocturnal hemoglobinuria (PNH) is a ultra-uncommon blood issue occurring in the stem cells of the bone marrow, which are hereditarily described by the somatic mutation in the phosphatidylinositol glycan protein A (PIG-A) gene. PNH for the most part happens in the mid-30s. Around 10% patients can experience PNH indications at 21 years old or prior. Around 1 to 5 people for every million individuals in the United States are evaluated to experience the ill effects of PNH. Expanding adoption of top notch therapeutics, increasing aged populace, and rise of biologics are probably going to be a portion of the essential development stimulants for the market.
To Clear Any Query about Report, Please Refer Link @ https://www.crystalmarketresearch.com/send-an-enquiry/HC111922
Table of Contents:
1.Introduction
2.Executive Summary
2.1.Key Highlights
3.Market Overview
..
5.Paroxysmal Nocturnal Hemoglobinuria (PNH) Treatment Market, By Treatment
5.1.Introduction
5.2.Global Paroxysmal Nocturnal Hemoglobinuria (PNH) Treatment Revenue and Market Share by Treatment(2014-2018)
5.2.1.Global Paroxysmal Nocturnal Hemoglobinuria (PNH) Treatment Revenue and Revenue Share by Treatment(2014-2018)
5.3.Stem Cell Transplant
5.3.1.Global Stem Cell Transplant Revenue and Growth Rate (2014-2018)
5.4.Medication
5.4.1.Global Medication Revenue and Growth Rate (2014-2018)
5.5.Blood Transfusion
5.5.1.Global Blood Transfusion Revenue and Growth Rate (2014-2018)
Continued..
North America rules the worldwide PNH treatment market because of the ascent in the quantity of blood and bone marrow related illnesses, accessibility of supportive repayment schemes, and increment in awareness about the early identification of the sickness in the area.
What our Report offers:
Paroxysmal Nocturnal Hemoglobinuria (PNH) Treatment Market share assessments for the regional and country level segments.
Paroxysmal Nocturnal Hemoglobinuria (PNH) Treatment Market share analysis of the top industry players.
Strategic recommendations for the new entrants.
Competitive landscaping mapping the key common trends.
For More Discounts Offers on Report @ https://www.crystalmarketresearch.com/check-discount/HC111922
About Crystal Market Research:
Crystal Market Research is a U.S. based market research and business intelligence company. Crystal offers one stop solution for market research, business intelligence, and consulting services to help clients make more informed decisions. It provides both syndicated as well as customized research studies for its customers spread across the globe. The company offers market intelligence reports across a broad range of industries including healthcare, chemicals & materials, technology, automotive, and energy.
Contact Us:
Judy
304 South Jones Blvd, Suite 1896,
Las Vegas NV 89107,
United States
Toll Free: +1-888-213-4282
Email: sales@crystalmarketresearch.com
This release was published on openPR.
Permanent link to this press release:
Copy
Please set a link in the press area of your homepage to this press release on openPR. openPR disclaims liability for any content contained in this release.
You can edit or delete your press release Paroxysmal Nocturnal Hemoglobinuria (PNH) Treatment Market offers huge growth opportunities for the future | Akari Therapeutics, Ra Pharmaceuticals, Alexion Pharmaceuticals, Apellis Pharmaceuticals, Ra Pharmaceuticals here
News-ID: 1568305 • Views: …
More Releases from Crystal Market Research - Healthcare
Viral Vector And Plasmid Dna Manufacturing Market Outlook 2019 | Business Develo …
Crystal Market Research Present Advance research on - Viral Vector And Plasmid Dna Manufacturing Market, approximates that the Viral Vector And Plasmid Dna Manufacturing Industry size is anticipated to flourish at a significant CAGR in the future.
The Viral Vector and Plasmid DNA Manufacturing Market has encountered significant development over the recent years and is anticipated to grow tremendously over the forecast period. Viral vectors and plasmid DNA manufacturing usually incorporates…
Medical Digital Imaging Systems Market | Research Report 2019-2025 | Major Compa …
Crystal Market Research Present Advance research on "Medical Digital Imaging Systems Market", approximates that the Medical Digital Imaging Systems Industry size is anticipated to flourish at a significant CAGR in the future.
The Medical Imaging is the process and technique of making the visual portrayals of the inside of the body for the purpose of medical intervention and clinical analysis, just as visual portrayal of the functioning of certain tissues (physiology)…
Medical Device Complaint Management Market | Research Report 2019-2025 | Major C …
Crystal Market Research Present Advance research on "Medical Device Complaint Management Market", approximates that the Medical Device Complaint Management Industry size is anticipated to flourish at a significant CAGR in the future.
The manufacturers of medical gadget must keep record and also track the complaints of customer as per the Quality System Regulation (QSR) characterized in the 21 CFR Part 820. Furthermore, the FDA Part 803 guidelines need the firms…
Veterinary Molecular Diagnostics Market | Research Report 2019-2025 | Major Comp …
The Universal Veterinary Molecular Diagnostics Market is anticipated to observe supported development over the foreseen period. The major development factor for the growth of Veterinary Molecular Diagnostics is the positive development in the beverage sector. Moreover, expanding canned food preference and increment in extra cash of the customers is the primary factors which are driving the market. Moreover, high recovery and recycling rate of the metal cans is anticipated to…
More Releases for PNH
Major Growth Driver Identified in 2025 Paroxysmal Nocturnal Hemoglobinuria (PNH) …
Use code ONLINE30 to get 30% off on global market reports and stay ahead of tariff changes, macro trends, and global economic shifts
Paroxysmal Nocturnal Hemoglobinuria (PNH) Market Size Valuation Forecast: What Will the Market Be Worth by 2025?
The market of paroxysmal nocturnal hemoglobinuria (PNH) has been experiencing a significant expansion in the recent past. The market, which was valued at $4.24 billion in 2024, is projected to reach $4.68 billion…
Rising Prevalence Of Blood And Bone Marrow Disorders Fueling The Paroxysmal Noct …
The Paroxysmal Nocturnal Hemoglobinuria (PNH) Market Report by The Business Research Company delivers a detailed market assessment, covering size projections from 2025 to 2034. This report explores crucial market trends, major drivers and market segmentation by [key segment categories].
What Is the Expected Paroxysmal Nocturnal Hemoglobinuria (PNH) Market Size During the Forecast Period?
The market for paroxysmal nocturnal hemoglobinuria (PNH) has seen a swift expansion in recent times. The expected growth from…
Major Market Shift in Paroxysmal Nocturnal Hemoglobinuria (PNH) Industry: Innova …
What Is the Forecasted Market Size and Growth Rate for the Paroxysmal Nocturnal Hemoglobinuria (PNH) Market?
The paroxysmal nocturnal hemoglobinuria (PNH) market has grown rapidly in recent years. It will rise from $4.24 billion in 2024 to $4.68 billion in 2025, at a CAGR of 10.4%. This growth is due to the rising demand for treatments for PNH, increasing disposable incomes, government initiatives, and rising healthcare spending.
The paroxysmal nocturnal hemoglobinuria (PNH)…
Paroxysmal Nocturnal Hemoglobinuria (PNH) Treatment Market Size Hits USD 14.73 b …
According to Value Market Research, the global Paroxysmal Nocturnal Hemoglobinuria (PNH) Treatment Market size is projected to experience substantial growth, with an anticipated market size of approximately USD 14.73 billion by 2032. This growth represents a significant increase from the USD 5.39 billion recorded in 2023, reflecting a robust compound annual growth rate (CAGR) of 11.82% over the forecast period from 2024 to 2032. This upward trajectory underscores the increasing…
Battling Blood Disorders: PNH Market Trends and Growth Forecast 2024-2033
The paroxysmal nocturnal hemoglobinuria (pnh) market size has grown rapidly in recent years. It will grow from $3.84 billion in 2023 to $4.24 billion in 2024 at a compound annual growth rate (CAGR) of 10.5%. The growth in the historic period can be attributed to growing demand for paroxysmal nocturnal hemoglobinuria treatment, rising disposable incomes, government initiatives, rising healthcare expenditure.
The paroxysmal nocturnal hemoglobinuria (pnh) market size is…
PNH and aHUS Market Development 2021 | Growth Analysis and Dynamic Demand by 202 …
A Latest intelligence report published by The Insight Partners with title “PNH and aHUS Market Outlook to 2028. A detailed study accumulated to offer Latest insights about acute features of the PNH and aHUS Market . This report provides a detailed overview of key factors in the PNH and aHUS Market and factors such as driver, restraint, past and current trends, regulatory scenarios and technology development. A thorough…